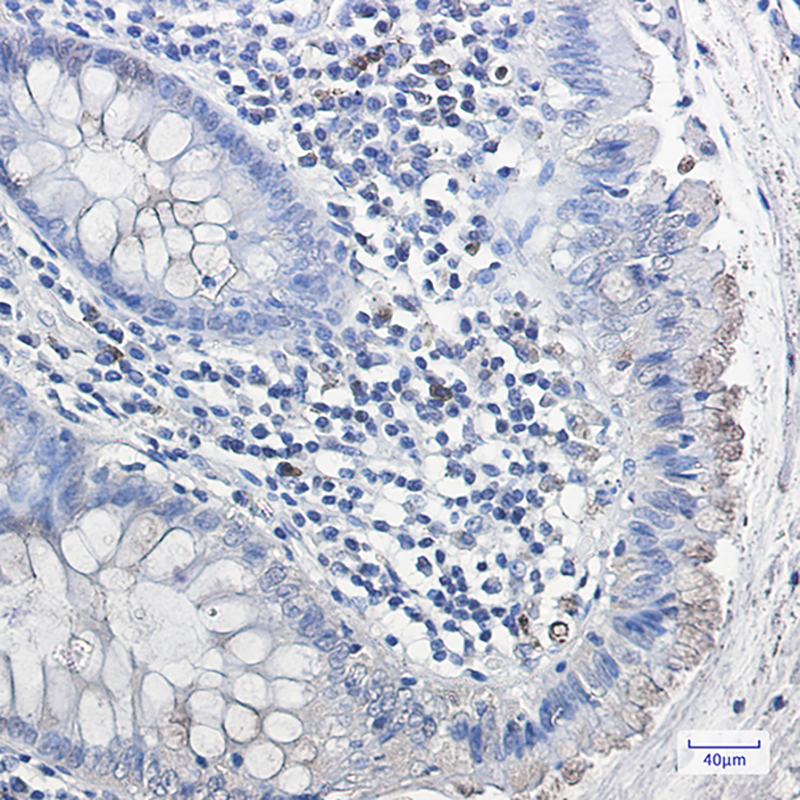

别名:Alpha gal A; GALA; Galactosidase; alpha; GLA; Melibiase应用:WB,IHC,IP
反应种属:Human
规格:50μl/100μl
| Description |
|---|
| Defects in GLA are the cause of Fabry disease (FD) [MIM:301500]. FD is a rare X-linked sphingolipidosis disease where glycolipid accumulates in many tissues. The disease consists of an inborn error of glycosphingolipid catabolism. |
| Specification | |
|---|---|
| Aliases | Alpha gal A; GALA; Galactosidase; alpha; GLA; Melibiase |
| Entrez GeneID | 2717 |
| Swissprot | P06280 |
| WB Predicted band size | Calculated MW: 49 kDa; Observed MW: 49 kDa |
| Host/Isotype | Rabbit IgG |
| Storage | Store at 4°C short term. Aliquot and store at -20°C long term. Avoid freeze/thaw cycles. |
| Species Reactivity | Human |
| Immunogen | A synthetic peptide of human Galactosidase alpha |
| Formulation | 50mM Tris-Glycine(pH 7.4), 0.15M NaCl, 40% Glycerol, 0.01% Sodium azide and 0.05% BSA |
| Application | |
|---|---|
| IP | 1/20 |
| WB | 1/500-1/1000 |
| IHC | 1/50-1/100 |
![]() |
Western blot analysis of Galactosidase alpha in K562 lysates using Galactosidase alpha antibody. |
![]() |
Immunohistochemistry analysis of paraffin-embedded Human colon cancer using Galactosidase alpha antibody.High-pressure and temperature Sodium Citrate pH 6.0 was used for antigen retrieval. |
本公司的所有产品仅用于科学研究或者工业应用等非医疗目的,不可用于人类或动物的临床诊断或治疗,非药用,非食用。
暂无评论
本公司的所有产品仅用于科学研究或者工业应用等非医疗目的,不可用于人类或动物的临床诊断或治疗,非药用,非食用。
中文

发表回复